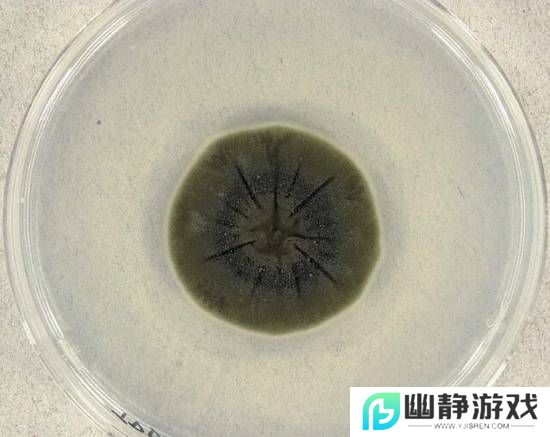
本站

切尔诺贝利发现耐高辐射黑色真菌 还能“吃”辐射
时间: 2025-11-14 09:45:53
小编: 网友
1986年4月26日,位于乌克兰普里皮亚季镇附近的切尔诺贝利核电站4号反应堆发生爆炸,这仍是人类历史上最严重的核灾难。事故后,该区域划定了一片30公里范围的隔离区。这片荒芜之地即便在事故发生数十年后的
1986年4月26日,位于乌克兰普里皮亚季镇附近的切尔诺贝利核电站4号反应堆发生爆炸,这仍是人类历史上最严重的核灾难。事故后,该区域划定了一片30公里范围的隔离区。这片荒芜之地即便在事故发生数十年后的今天,辐射水平依然很高,人类定居与居住活动在此受到严格限制。

然而,科学家们在这片隔离区内发现了一种出人意料的“幸存者”:一种具有强适应能力的黑色真菌,学名为球孢枝孢菌(Cladosporium sphaerospermum) 。切尔诺贝利灾难发生后,科学家观察到4号反应堆的墙体上出现了一片片黑色菌群,这些真菌竟在辐射最强的区域旺盛生长。

这种真菌已能适应对绝大多数生命形式而言足以致命的辐射强度。更令人惊叹的是,它还具备“以辐射为食”的能力——能将辐射作为能量来源,其原理类似植物通过光合作用利用阳光获取能量。
后续研究发现,球孢枝孢菌(C. sphaerospermum)以及其他一些黑色真菌种类,如皮炎王氏霉(Wangiella dermatitis)、新型隐球菌(Cryptococcus neoformans)体内都含有黑色素——这种色素正是决定人类肤色的物质。但在这些真菌体内,黑色素却发挥着截然不同的作用:它能吸收辐射,并将辐射转化为可利用的能量,这使得真菌能够在辐射强度极高的区域生长。
这是一种非凡的适应性表现,让我们得以一窥生命如何在地球上某些最极端、最恶劣的环境中蓬勃生存。
球孢枝孢菌(Cladosporium sphaerospermum)隶属于一类被称为“嗜辐射真菌(radiotrophic fungi)”的真菌群体。嗜辐射生物能够捕获并利用电离辐射,为自身的代谢过程供能。
更令人惊讶的是,当科学家把这种真菌送上国际空间站时,它不仅存活下来——还茁壮成长。它形成了一层生物膜(biofilm),能阻挡多达84%的入射宇宙辐射。如今,科学家正研究它作为一种潜在的“活体屏障”,以保护宇航员在深空任务中免受辐射伤害。
